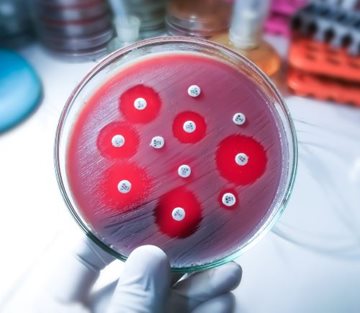
Agar plate covered in bacteria and circles where some bacteria have died

Heteroresistance: An Insidious Form of Antibiotic Resistance
“There will be growing deaths due to antibiotic resistance in the future; by 2050, potentially 10 million per year,” Weiss stated during a scientific session at ASM Microbe 2024. However, “It could be even worse if heteroresistance and other subpopulation behaviors that, right now, are not even classified as resistance are taken into account.”
The Mechanics of Heteroresistance
Heteroresistance—when a single bacterial strain harbors both susceptible and resistant cells—occurs among diverse bacteria and in the context of a whole spate of antibiotics: fluoroquinolones, aminoglycosides, β-lactams, you name it. The phenomenon is defined as the presence of a small, resistant subpopulation of bacteria with an 8-fold increase in minimal inhibitory concentration (MIC) for a drug relative to the main susceptible population (though the magnitude of that increase varies depending on the study). Whether the MIC intersects with the breakpoint of an antibiotic (a pre-determined range that classifies an organism as susceptible or not) is an important consideration, along with the frequency of resistant cells.
The heterogeneity inherent to heteroresistance can develop in different ways. For example, in some gram-negative bacteria, cells increase amplification of resistance genes (e.g., β-lactamases), bolstering the number of copies available to fight a drug and giving rise to resistant subpopulations. Mutations in—or altered expression of—antibiotic targets, transporters or core genes in cells, and co-factors associated with their function, are other potential mechanisms.

Here Until It's Not
What’s problematic (and clinically frustrating) about heteroresistance is that it is unstable—the abundance of resistant cells waxes and wanes depending on the presence or absence of antibiotic.In a heteroresistant population, “susceptible cells usually grow faster, and resistant cells usually have a fitness cost—when there's no drug, the resistant cells are at a disadvantage,” Weiss explained. “But if you add a drug, everything flips to where now only the resistant ones can survive. Even though they have a fitness disadvantage, they're still the only ones who can grow, so they end up taking over.” Because the bacteria can produce both resistant and susceptible cells, if you take away the drug again, the susceptible population will grow quickly and outcompete the resistant one. Moreover, resistant bacteria can revert to susceptible phenotypes if, for example, they reduce expression of resistance genes or develop compensatory mutations that mitigate the fitness cost of resistance when there is nothing to resist.
Such transience is a diagnostic nightmare. While an isolate may be resistant in a patient, once it is sampled and prepared for antimicrobial susceptibility testing (AST)—in which it is first grown on media that does not contain antibiotics—the number of resistant cells falls back down to baseline, essentially fading into the background. Because of this, the isolate could be classified as susceptible when it is resistant in a clinical context, giving an inaccurate picture of the bacteria causing a patient’s infection and paving the way for treatment failure.
An Increased Risk of Treatment Failure
This is the chief concern about heteroresistance—resistant cells may sneakily proliferate upon exposure to an antibiotic, creating a situation where the drug is no longer effective. Mathematical modeling suggests this is a likely possibility, and several studies exploring heteroresistance in Staphylococcus aureus and Acinetobacter baumanii, among others, have similarly lent credence to this unfortunate outcome. For example, a retrospective analysis of pediatric leukemia patients with bloodstream infections caused by S. epidermidis reported that vancomycin heteroresistance increased the risk of treatment failure and poor clinical response.In mice, colistin—the last-line antibiotic for gram-negative infections—was unable to rescue animals infected with heteroresistant strains of carbapenem-resistant Klebsiella pneumoniae. Additional work has shown that stress from host innate immune defenses can indirectly select for a resistant subpopulation of heteroresistant bacteria during infection, even in the absence of antibiotic treatment. The result: when the drug is used for treatment, it no longer works. These findings suggest the host may have a role to play in promoting and maintaining heteroresistance in vivo.
Though heteroresistance has been on the scientific radar since 1947, there are many questions researchers still have about its clinical impacts, including what it means in terms of patient morbidity and mortality and how widespread it is.
“The prevalence of heteroresistance [is] very diverse, it’s underreported and it’s underappreciated,” said Vanthida Huang, Pharm.D., BSPHM, FCCP, a professor in the College of Pharmacy at Midwestern University. Depending on the study, drug, bacteria and detection methods, prevalence estimates range from fractions of a percent to upward of 60% of isolates analyzed. Weiss emphasized that more studies with human patients are required to get a firm handle on these knowledge gaps and, in turn, the full extent of the AMR crisis.
Heteroresistance Detection: A Clinical Quandry
There’s a reason why so much about heteroresistance is still hazy: studying and detecting it is tough. This is largely due to a dearth in standard detection methods. “There’re many different individual tests that we use,” Huang said. “But what we still have a hard time with is the feasibility of the workflow to be able to identify heteroresistance in the clinical lab,” so clinicians can use it to inform their treatment plans.
Currently, the gold standard method of heteroresistance detection is a population analysis profile (PAP), in which bacterial cultures are plated on agar plates with 2-fold increasing concentrations of an antibiotic; based on the proportion of surviving bacteria at or above the breakpoint concentration, the isolate is classified as resistant, susceptible or heteroresistant. While the assay quantitatively determines the frequency of a resistant subpopulation—a key aspect for pinning down heteroresistance—it takes days to complete and is expensive.
Other methods (Etests and disc diffusion assays) are non-quantitative and only detect resistant subpopulations at high frequency—those present at a low frequency may fly under the radar. Indeed, most AST methods work under the assumption that all bacterial cells in an isolate are the same. They are generally not sensitive enough to capture the heterogeneity that epitomizes heteroresistance, when a resistant subpopulation may only make up a small fraction of cells. Depending on the test used, and frequency of resistant cells, there may be discrepancies in how an isolate is classified, which can cause confusion in how best to treat it.
There are emerging advancements that could address some of these shortcomings. Molecular methods that rely on microbial DNA (e.g., droplet digital PCR, whole genome sequencing) are possible alternatives, in that they can be quick, relatively cheap and comprehensive. That these methods rely on genotypic markers of resistance—some of which may not be known for certain bacterial/antibiotic pairings—is a downside, and there are cases where phenotypic changes may not result from discernible genetic changes. Other strategies rope in artificial intelligence to increase detection efficiency and sensitivity, such as by pairing microscopy with AI to classify susceptible and resistant phenotypes down to the single cell level.
“[There is a] lack of a uniform standard of validation methods that are feasible to incorporate in our clinical labs. Establishing these methods is really important for us in the heteroresistance field,” Huang stated.
Where Do We Go From Here?
With better detection comes better treatment—the ability to easily determine whether someone is harboring a heteroresistant isolate can arm health care practitioners with the information they need to treat patients as quickly and effectively as they can.
What that treatment looks like requires additional investigation. Studies suggest combination antibiotic therapy is a promising approach, especially if dealing with bacteria exhibiting heteroresistance to multiple drugs—a drug may not work against 1 subpopulation but is effective against another. Huang noted the solutions will likely be multi-factorial, including leaning into precision medicine practices, finding effective detection methods with low labor costs and uncovering new antibiotics to expand the pool of available treatments. In Huang’s eyes, combating the problem will ultimately be a collective effort. “All of us can think about what we can do to overcome heteroresistance.”
Research in this article was presented at ASM Microbe, the annual meeting of the American Society for Microbiology, held June 13-17, 2024, in Atlanta.
From discovering new antibiotics, to implementing policies that steward existing drugs in the antimicrobial toolbox, the Fall 2023 issue of Microcosm explores antimicrobial resistance (AMR) and how to combat one of the largest threats to global public health and the environment.
